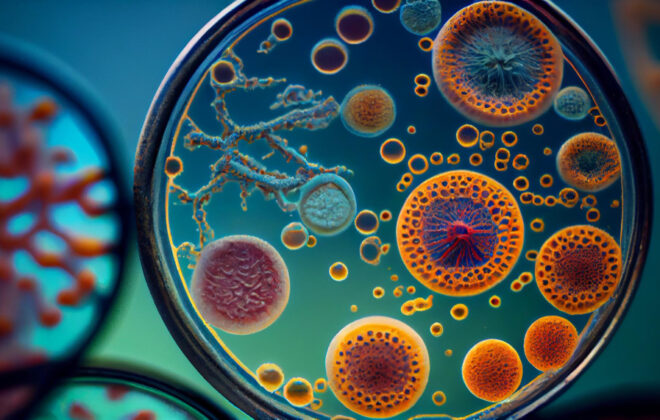

Nutrigenômica e o exercício
A nutrigenômica é uma disciplina que estuda a interação entre a nutrição e os genes, e como essa interação pode influenciar o desempenho esportivo. Por meio da análise de informações genéticas individuais, é possível identificar genes específicos que estão envolvidos na resposta ao exercício, recuperação muscular, metabolismo energético e outros processos fisiológicos relevantes para atletas. Compreender essas informações genéticas permite aos profissionais de saúde e nutricionistas esportivos personalizar estratégias alimentares e nutricionais para otimizar o desempenho e a recuperação dos atletas.
Um dos genes analisados no teste genético BioSport da Biogenetika é o gene ACTN3, conhecido como “gene do atleta“. Esse gene está associado à produção de uma proteína muscular chamada alfa-actinina-3, que desempenha um papel importante na contração muscular rápida. Existem duas variantes desse gene: uma que produz a alfa-actinina-3 e outra que não a produz. A presença da alfa-actinina-3 está associada a um melhor desempenho em atividades que requerem explosão muscular, como sprints e levantamento de peso. Com base nessa informação genética, os profissionais podem adaptar a dieta e o treinamento dos atletas para otimizar seus resultados com base em suas características genéticas individuais.
Outro exemplo de gene analisado no teste BioSport é o gene COL5A1, que está relacionado à produção de colágeno, uma proteína essencial para a saúde dos tendões e ligamentos. Variantes genéticas nesse gene podem influenciar a estrutura e a resistência dos tecidos conjuntivos, e influenciar a qualidade e a resistência do colágeno produzido. Compreender a predisposição genética de um atleta em relação à produção de colágeno pode ajudar na prevenção de lesões relacionadas aos tecidos conjuntivos, permitindo um planejamento adequado de treinamento, suplementação e recuperação.
Além dos genes específicos, o teste genético BioSport também avalia marcadores genéticos relacionados ao metabolismo dos carboidratos e gorduras. Essas informações permitem ajustar a dieta dos atletas de acordo com suas necessidades metabólicas individuais, garantindo um fornecimento adequado de nutrientes essenciais para o desempenho e recuperação muscular.
Os benefícios do teste genético BioSport vão além da personalização da nutrição esportiva. Compreender as características genéticas dos atletas permite um treinamento mais direcionado, evitando o “overtraining” e maximizando os resultados. Além disso, a identificação de predisposições genéticas para lesões ou inflamação pode direcionar medidas preventivas específicas, como o uso de suplementos anti-inflamatórios ou modificações no treinamento.
Em resumo, a aplicação da nutrigenômica no esporte, por meio do teste genético BioSport, oferece aos atletas e seus treinadores informações valiosas sobre suas características genéticas individuais, permitindo a personalização de estratégias alimentares, suplementação e treinamento. Isso resulta em um melhor aproveitamento do potencial genético, otimização do desempenho e minimização dos riscos de lesões. Através da análise dos genes envolvidos na resposta ao exercício, metabolismo energético e recuperação muscular, é possível identificar os nutrientes e alimentos que podem favorecer a expressão gênica relacionada ao desempenho físico.
Outro exemplo, é o gene PPARGC1A que está envolvido na regulação do metabolismo energético e na produção de mitocôndrias, as estruturas responsáveis pela produção de energia nas células musculares. Variantes genéticas nesse gene podem influenciar a resposta ao exercício aeróbico e à ingestão de nutrientes específicos, como a ingestão de ácidos graxos ômega-3, que tem sido associada a benefícios no desempenho físico e recuperação muscular. Com base nessa informação genética, os atletas podem ajustar sua dieta para incluir alimentos ricos em ômega-3, como peixes gordurosos, sementes de linhaça e chia, a fim de potencializar seu desempenho.
A nutrigenômica aplicada ao esporte, por meio do teste genético BioSport, oferece uma abordagem personalizada e baseada em evidências para a nutrição esportiva. Compreender como os nutrientes e alimentos interagem com os genes dos atletas permite a otimização de sua expressão gênica relacionada ao desempenho físico, maximizando seu potencial atlético.
Desta forma, os atletas conhecendo suas características genéticas individuais, é possível uma abordagem mais precisa e eficaz na nutrição e treinamento esportivo. Isso resulta em um melhor desempenho, recuperação aprimorada e minimização de riscos, proporcionando uma vantagem competitiva no mundo esportivo.
Akhmetov II, Popov DV, Astratenkova IV, et al. [Using Molecular Genetic Methods for Prognosis of Aerobic and Anaerobic Performance in Athletes]. Fiziol Cheloveka. 2008;34(3):86‐91.
Alfred T, Ben-Shlomo Y, Cooper R, et al. ACTN3 genotype, athletic status, and life course physical capability: meta-analysis of the published literature and findings from nine studies. Hum Mutat. 2011;32(9):1008‐1018. doi:10.1002/humu.21526
Abrahams Y, Laguette MJ, Prince S, Collins M. Polymorphisms within the COL5A1 3′-UTR that alters mRNA structure and the MIR608 gene are associated with Achilles tendinopathy. Ann Hum Genet. 2013;77(3):204‐214. doi:10.1111/ahg.12013
Ahmad S, Rukh G, Varga TV, et al. Gene × physical activity interactions in obesity: combined analysis of 111,421 individuals of European ancestry. PLoS Genet. 2013;9(7):e1003607. doi:10.1371/journal.pgen.1003607

Como faço pra entrar em contato com vocês